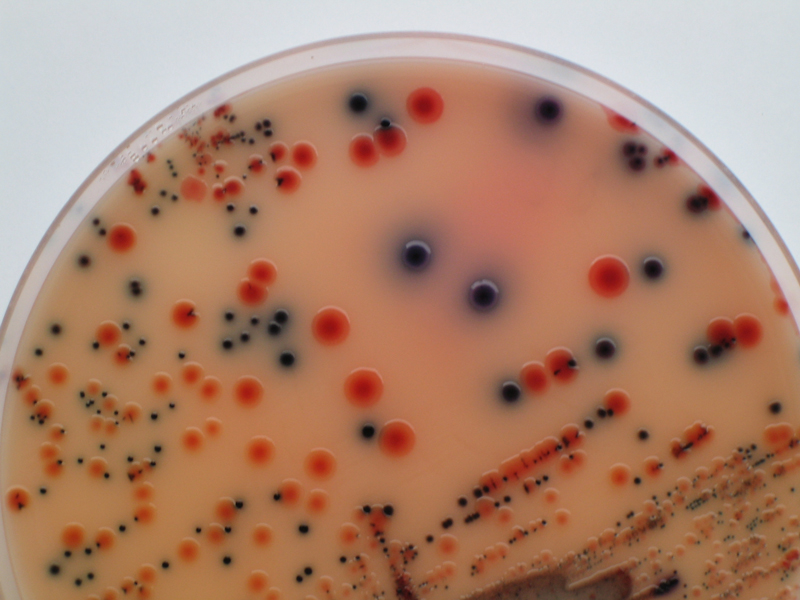

Apparue vers le milieu des années 2000, la cosmétique « fait maison » (alias Do it yourself) est devenue une tendance omniprésente, d’abord sur le web, via des blogueuses passionnées par les produits de beauté, puis dans les magazines féminins ou bio, dans les librairies et même dans certains reportages télévisés. Au point qu’elle s’apprend aujourd’hui dans des ateliers et qu’elle fait surtout le bonheur de sociétés qui se sont spécialisées dans la vente d’ingrédients, en ligne ou dans des vraies boutiques.
Des motivations multiples
De façon incontestable, de plus en plus de femmes – car c’est un loisir visiblement essentiellement féminin - concoctent leurs produits cosmétiques dans leur cuisine. Pourquoi cette passion, apparue à peu près en même temps que « l’explosion » du marché de la cosmétique bio ?
Comme souvent, il serait inexact de donner une seule explication à cette tendance. Les causes de ce vrai phénomène de mode sont multiples. On peut en l’occurrence parler d’une convergence de plusieurs tendances et besoins, portant sur la santé, sur l’économie et enfin sur les modifications sociétales.
Concernant ce dernier point, nous pensons ici à un vrai retour au « faire soi-même ». Déjà en 2003, dans son numéro du 1er décembre, la revue professionnelle Métro écrivait que « le virus du ‘faire soi-même’ se propage en France » et que « 19 millions de Français de plus de 15 ans déclarent pratiquer un loisir créatif et la moitié y consacrent plus de six heures par mois ». La beauté (cosmétique mais aussi bijoux), n’a donc pas échappé à cette tendance, avec un côté « C’est moi qui l’ai fait », valorisant pour l’estime personnelle, de même que le fait de se distinguer en ayant quelque chose d’unique, ou presque. « Faire ses cosmétiques, c’est chic », titrait le quotidien Le Monde en septembre 2009. Pourquoi cette explosion de cette forme de loisir ? Tout simplement, comme le soulignaient alors les journalistes, l’arrivée des 35 heures… et des RTT le 1er janvier 2001.
Puis, quelques années après est venue se greffer la crise économique mondiale de 2008. Dans un monde de plus en plus soumis aux inquiétudes sur notre avenir, à des scandales récurrents portant sur les productions industrielles, revenir à une forme plus artisanale des produits de consommation courante, en sortant de la standardisation – en gros une sorte de « retour aux sources » - a été également ressenti comme quelque chose de rassurant. Sortir des « diktat » des grands groupes industriels est une forme de résistance, qui s’exprime pleinement par l’économie collaborative (Airbnb, Uber, Blablacar, les fablabs, le mouvement des « Makers », les échanges de service…) - même si elle finit par avoir aussi ses dérives (cf. « l’ubérisation » de la société ») – ou le crowdfunding. A l’éclosion des RTT puis l’apparition de la crise est venue s’ajouter, en janvier 2009, la création du statut d’auto-entrepreneur. Sans oublier cet outil fabuleux qu’est Internet né lui aussi au tournant des années 2000, certes capable parfois du pire, mais aussi extraordinaire plate-forme de recherche et de partage d’informations. Tout ceci combiné ensemble a dopé une nouvelle façon de penser, de travailler et d’occuper ses loisirs.
En parallèle de ces grands mouvements sociétaux, mais étroitement imbriquée à ce qui vient d’être évoqué, s’est développé une inquiétude majeure, celle relative à la santé et à l’environnement. Lutter contre le gaspillage, contre la surconsommation, contre l’obsolescence programmée, pratiquer le recyclage, avec un certain éloge de la lenteur (prendre le temps pour faire bien les choses), tout cela fait sens. Une tendance qui reste forte en ce début des années 2020.
On ne s’étonnera dès lors pas de lire, en parcourant les blogs et webzines des « cosméteuses » (comme se sont baptisées certaines adeptes de la cosmétique fait maison), que celles-ci recherchent « une nouvelle façon de consommer ».

Faire soi-même ses cosmétiques, c’est aller à l’essentiel, comme si on puisait directement dans la nature pour prendre soin de sa beauté (image Jcomp via Freepik).
Ceci passe alors par le souhait d’éviter une « liste trop longue de dizaines d’ingrédients » et les « mauvais ingrédients cosmétiques »: parabènes et autres conservateurs, silicones, ingrédients éthoxylés, parfums et colorants synthétiques, substances irritantes, perturbateurs endocriniens, etc., issus de la « chimie lourde », sans parler de l’excès « d’excipients inertes ». Face aux étiquettes auxquelles « on ne comprend rien », il est « important de savoir ce que contiennent les produits », de « contrôler la composition », de « lutter contre la pollution en utilisant des produits le moins possible transformés », avec « des ingrédients de la nature, en choisissant ceux qui sont biodégradables, ce qui est mieux pour notre peau et pour la planète ». La cosmétique fait maison offre aussi une « simplicité rassurante » et de pouvoir « connaître tous les effets du produit », étant « plus efficace » car contenant « jusqu'à 90 à 100% de principes actifs ». Certains soulignent même que les formules sont « 100% actives, l'eau étant remplacée par un hydrolat et l'huile synthétique par une huile végétale ». Mais ce sont autant d’arguments qui, notons-le d’ores et déjà, s’appliquent aussi pour la plupart à la cosmétique bio certifiée.
Faire ses cosmétiques soi-même, cela permet de « personnaliser les recettes », de « développer sa créativité » et est « ludique ». Enfin, mais nous y reviendrons, cela « permet de faire des économies », « jusqu’à 5, 10 ou 20 fois moins cher », et n’est « finalement pas si difficile que ça ». Des motivations que l’on retrouve aussi, et qui l’expliquent, dans l’engouement parallèle pour la cuisine traditionnelle, avec l’explosion des ateliers de cuisine et l’apparition du label… « fait maison » dans la restauration.
Remarquons ici un point qui séduit les cosméteuses, surtout les plus jeunes : à l’instar de ce que l’on constate justement en cuisine, nombre de recettes proposées sont alléchantes dès leur appellation, quand on lit que ces laits, crèmes ou gommages sont à base de « passion et cassis », « amande et pomme », « abricot et muguet ». Comment, avec raison, ne pas céder à la tentation ?
Faire ses propres cosmétiques : pas si simple en fait
Mais derrière cet enthousiasme, la réalité est parfois plus dure. Ce sont les cosméteuses eux-mêmes qui le disent, en particulier celles qui ont été déçues de l’expérience.
Stérilisation obligatoire du matériel (même si on utilise des conservateurs naturels), la contamination bactérienne étant le premier des risques ; nécessité de tenir un inventaire précis de chaque ingrédient (date d’achat, date d’ouverture, durée de conservation) ; mode de stockage adapté (température, lumière… gare à l’oxydation et/ou au rancissement) ; huiles essentielles (largement mises en avant dans des recettes qui circulent sur Internet) qui ne sont pas des ingrédients innocents comme on le sait (une erreur de dosage peut avoir de lourdes conséquences) : au final fabriquer ses cosmétiques nécessite une méthode, une maîtrise et une hygiène parfaites. Innombrables sont les essais partis à la poubelle, sans oublier les produits réussis mais qui n’ont tenu que quelques jours. Quant au fait que l’on peut « faire des recettes réellement personnalisées », cela demande un savoir-faire que tout le monde n’a pas. Mal employés, mal dosés, mal associés, certains ingrédients peuvent avoir des conséquences graves. L’allergie potentielle de chaque ingrédient doit, en particulier, être testée. Le matériel doit aussi être impeccablement désinfecté/stérilisé, les mains parfaitement propres, et il faut idéalement porter des gants, une blouse et des lunettes de protection… comme cela est fait en usine !
Ces points de couleur sont autant de colonies de bactéries sur une boîte de culture microbiologique : la contamination bactérienne est le premier des risques quand on fait soi-même ses cosmétiques (image Cyb-cd via Wikimedia Commons).
Sur le plan de l’économie, beaucoup de personnes qui ont fait ou font eux-mêmes leurs cosmétiques l’avouent : si rapporté au pot ou au flacon fini, le volume ou le poids d’ingrédients utilisés ne coûte pas cher, il faut tenir compte du fait que la quantité requise correspond rarement à celle que l’on est obligé d’acheter. La plupart du temps, on a en de trop. On peut la réutiliser plus tard, mais parfois elle sera périmée avant. Et, beaucoup le soulignent, fabriquer ses produits, et surtout une large palette, devient vite « addictif », avec une liste des ingrédients à stocker qui s’allonge, avec un coût à l’avenant. Finalement, ce n’est donc pas toujours aussi économique qu’on le pensait, surtout si on ajoute le matériel de préparation ou le consommable. Quant à envisager d’en fabriquer plus pour le revendre ou l’offrir, c’est totalement à exclure : même pour un produit offert gracieusement, on se retrouve dans la position d’un fabricant, avec toutes les obligations, et surtout les risques, que cela entraîne.
Le « Fait maison », porte d’entrée vers la cosmétique bio
Si nombre de cosméteuses font des produits de qualité, avec une application quasi professionnelle, cela prend du temps, temps que la majorité des femmes, qui cumulent obligations familiales et occupations professionnelles n’ont pas à leur disposition. Faire des cosmétiques soi-même est par contre une bonne façon de comprendre la cosmétique, et notamment la cosmétique naturelle. En ce sens, le fait maison est clairement une excellente porte d’entrée vers la cosmétique certifiée.
Si on jette une nouvelle fois un coup d’œil sur la chronologie des évènements, la date d’apparition de la cosmétique fait maison est aussi celle où la cosmétique bio a fait elle-même son « coming-out », sortant des rayons des magasins spécialisés qui en étaient les avocats quasi exclusifs depuis des années. C’est en effet justement en mars 2005 que passa, très médiatisée, l’émission de télévision qui mit sous les feux de l’actualité les ingrédients douteux type parabènes. On connaît la suite... Constat immédiat évident : les adeptes de la cosmétique fait maison et celles/ceux de la cosmétique bio ont en fait le même désir d’une alternative beauté naturelle, plus saine.
Néanmoins, il faut se rappeler que les marques (même certifiées bio, qui offrent aujourd’hui la même efficacité et le même confort que les marques conventionnelles !) passent souvent un temps incroyablement long pour mettre au point des formulations actives et garantir une efficacité scientifiquement validée (et pas seulement ressentie). Ces marques bio n’ont pas attendu pour faire des formules où chaque composant a un rôle actif, et qu’en bio ceux-ci sont limités au strict nécessaire pour atteindre cette efficacité, tout en assurant un confort optimal. Rappelons aussi que leurs formules sont bien souvent plus simples, comparées à la cosmétique conventionnelle. Une simplicité qui tend même vers l’optimum pour celles qui se font les avocates de la « Slow cosmétique »® qu’affectionnent certains consommateurs. Enfin, un grand nombre de ces marques savent aussi concevoir aujourd’hui des « recettes gourmandes » qui font envie, voire des produits très ludiques, avec notamment des textures « caméléon » (huiles qui se transforment en lait, gels qui deviennent mousses, etc.).
Enfin, il ne faut pas nier que – malheureusement – plus on avance en âge, plus les besoins de notre peau, de nos cheveux (ou de nos dents : c’est aussi le domaine de la cosmétique) deviennent aigus et précis. Pour y répondre, c’est parfois une palette de très nombreux produits dont on peut avoir besoin, avec des efficacités très ciblées. Heureux/heureuse celui qui a alors vraiment le temps de transformer sa cuisine en laboratoire de fabrication… Mais au final, confier sa beauté à des spécialistes devient quand même tôt ou tard la solution la plus raisonnée et la plus raisonnable.
Pour conclure, laissons la parole à une de ces dames qui, à un moment a goûté au plaisir, réel, du fait maison mais a exprimé sur son blog le fond de la chose : « A chacun son métier et j'ai confiance dans le fait que certaines personnes/marques savent encore réaliser de bons produits avec de bonnes compositions dans le respect de la nature et des animaux ».

Le « fait maison » permet d’obtenir des cosmétiques agréables et dans l’ensemble efficaces. Mais il ne saurait concurrencer la haute technicité et l’expérience, souvent vieille de longues année, des marques bio engagées (image mcstewartt via Pixabay).